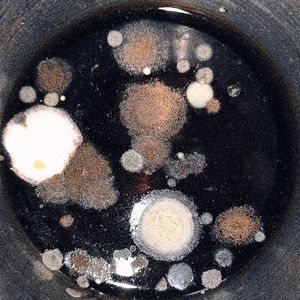
Fa1l

遇见了你
陈奕迅

就遗憾吧
耳朵便利店

你也会遗憾吗
王熠熠啊

偏偏这雨越下越大 (他们都说忘记就不会痛苦)
顾叮当

你也会遗憾吗
Zzh

无心的话
苏星婕

偏偏这雨越下越大
顾叮当

无心的话
吴玖炎

偏偏这雨越下越大
汐小羽

听了你的话
金钰晨
Fa1l
三暗水, Hide_ Môi Cam

暮光之境
你也会遗憾吗

我还想
北辰

梧桐立心已空 DJ
薄冰哥

偏偏这雨越下越大 (DJ德朋版)
顾叮当

你也会遗憾吗 (合唱版)
顾叮当, 克里

你也会遗憾吗
隗景辰

你也会遗憾吗
隗景辰

暮光
你也会遗憾吗

卫星
豪豪吃不胖

你也会遗憾吗 (伴奏)
王熠熠啊

你也会感到遗憾吗
谭真真, Neko团子, k-key

你也会有遗憾吗 (单簧管)
纯音乐

你也会有遗憾吗 (钢琴曲)
睡前音乐盒

你也会有遗憾吗 (手碟)
睡前音乐盒

你也会有遗憾吗 (风琴)
睡前音乐盒

你也会有遗憾吗 (排箫)
睡前音乐盒

你也会有遗憾吗 (竖琴)
纯音乐

你也会有遗憾吗 (长笛)
睡前音乐盒

你也会有遗憾吗 (吉他)
纯音乐